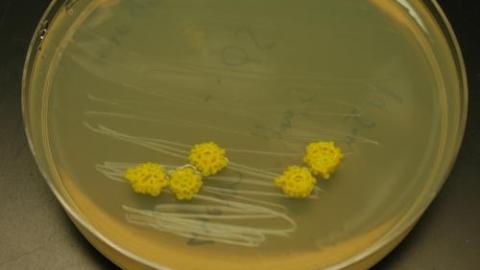

E. Coli Bacteria Engineered to Make Fuel
What’s the Latest Development?
Department of Energy scientists have engineered E. coli bacteria to digest switchgrass biomass, one of the most promising materials for creating alternative fuels. By synthesizing the plant’s sugars, the microbe creates hydrocarbons that have the properties of petrochemical fuels. Switchgrass has been used to create renewable fuels before but this is the first time it has created an alternative to all three major fuels: gasoline, diesel and jet.
What’s the Big Idea?
Advanced biofuels made from non-food crops and agricultural waste are widely believed to represent the best source of renewable liquid transportation fuels. “Unlike ethanol, which in this country is produced from corn starch, these advanced biofuels can replace gasoline on a gallon-for-gallon basis, and they can be used in today’s engines and infrastructures. The biggest roadblock to an advanced biofuels highway is bringing the cost of producing these fuels down so that they are economically competitive.”
Photo credit: shutterstock.com





